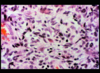

Neuro II path Flashcards
(14 cards)
Glioblastoma’s most important pathology feature
necrosis

Low grade astrocytoma
not very good to use chemo because not quickly dividing
can’t tell where it ends/begins, no vascular changes –> low grade
headache/seizures most common symptoms
treat w/ tenazolaminde and radiation

Astrocytoma
centrum semiovale; uniform nuclei, low cellularity, characteristic fibrillary background

cystic, not necrosis
pilocytic astrocytoma

Rosenthal fibers in pilocytic astrocytoma
these show up in glial scarring (astrocytes form glial scars)
grade III astrocytoma
see lots of nuclear activity, no vascular proliferation
atypia,

glioblastoma
could see cancer cells even in areas where you don’t see tumor

glioblastoma, tumor center
can see necrosis, vascular proliferation
hypercellularity

oligodendroglioma
“fried egg” appearance
tend to be responsive to chemo; 30s/40s is usual age of dx
test: LOHeterozygosity of chromosome 1P and 19Q (test with FISH)

perivascular pseudo-rosettes
epdendymoma

Medulloblastoma
A: hypercellularity
B: neuroblastic rosette aka homer-wright rosette
very responsive to radiation and chemotherapy
spread through CSF, drop mets can get into spinal cord

meningioma
SLOW growing (no herniation), extra-axial (outside of the brain parenchyma)
can progress to higher grade tumors, not very responsive to therapy

meningioma: characteristic whorls with variable degrees of central calcification (psammoma bodies) – most diagnostic histologic pattern of meningiomas
*note* one of the criteria for grade 1 or 2 meningioma is if it’s invaded into the brain tissue
Shwannoma (neurinoma, neurilemmoma)


